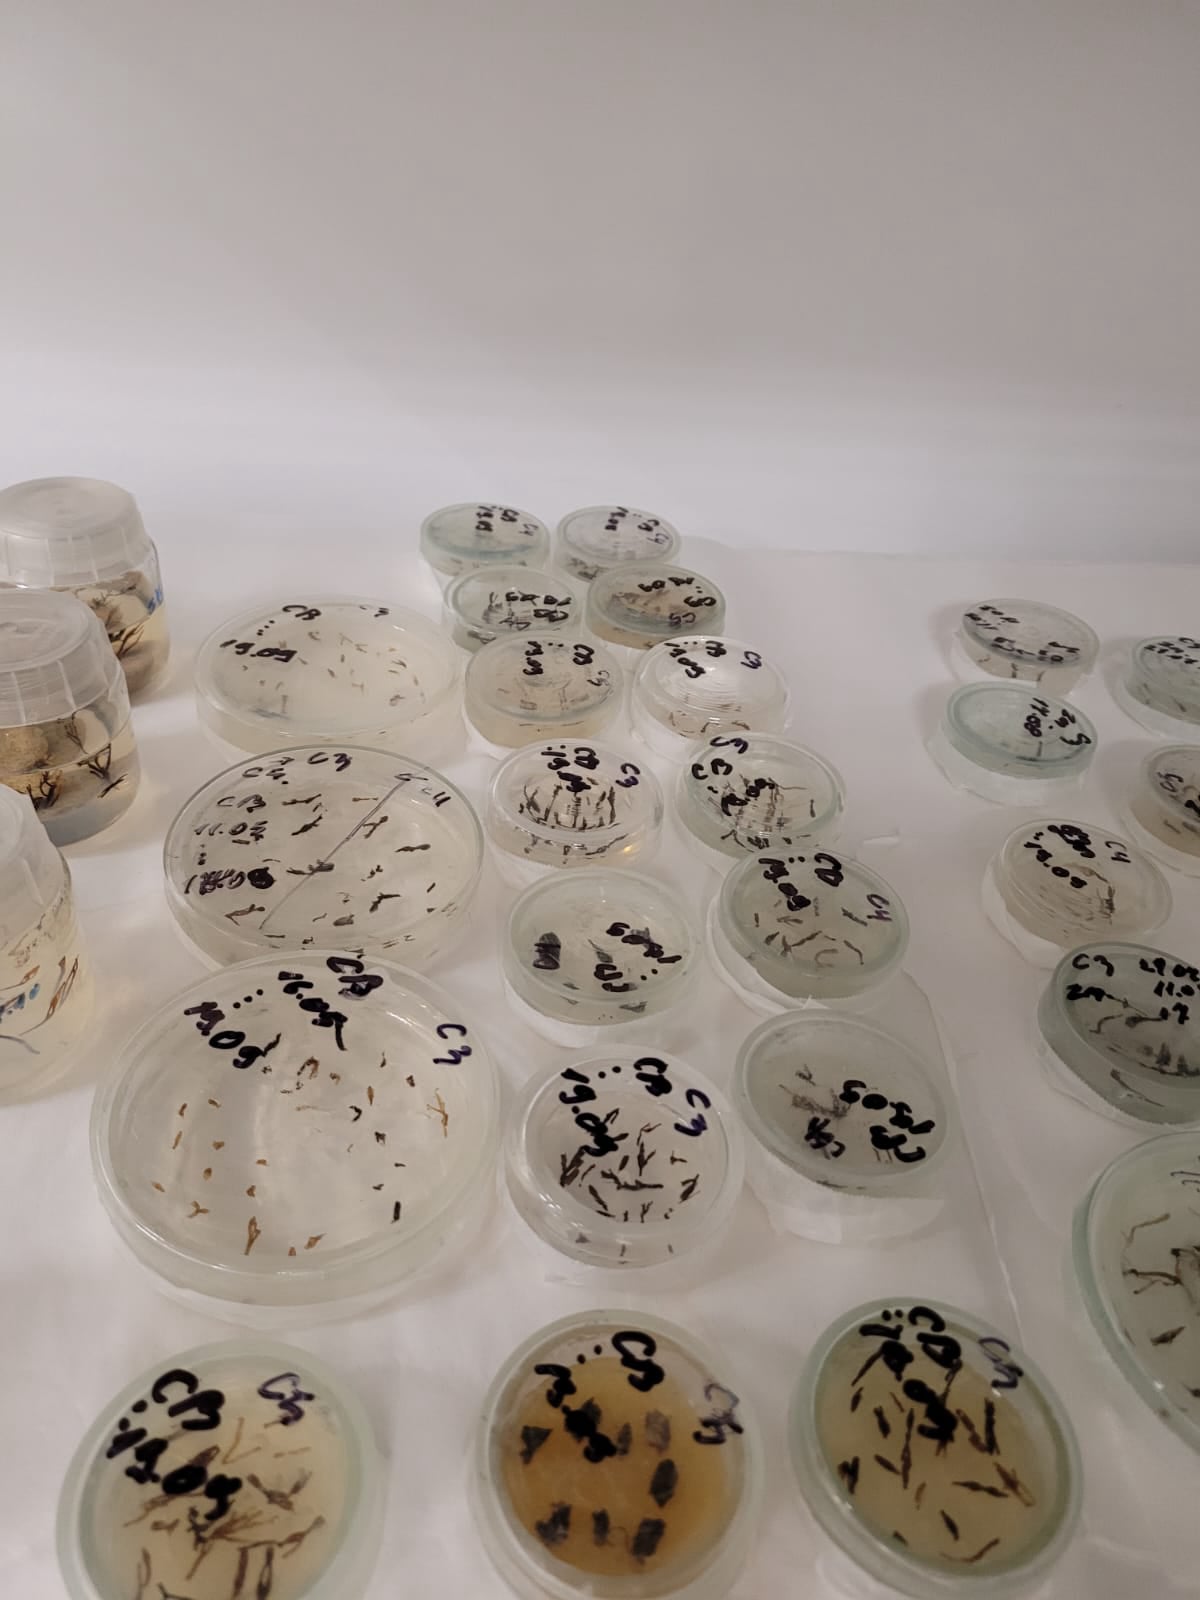
Mobirise Website Builder

Aprilie 2024
Evenimentul de închidere a proiectelor "Ecological Restoration on the Romanian Southern Coast" și ”Monitoring with Digital Technology”, finanțate prin Innovation EEA grants si realizat de catre Marinerus Explorer S.R.L. in parteneriat cu Institutul de Biologie București.